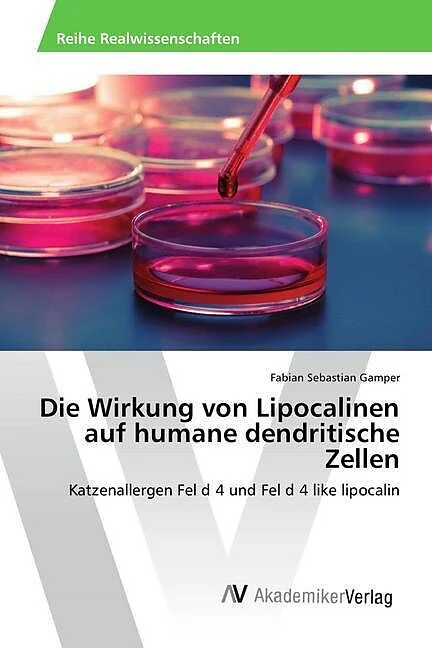
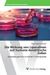

Wir verwenden Cookies und Analyse-Tools, um die Nutzerfreundlichkeit der Internet-Seite zu verbessern und für Marketingzwecke. Wenn Sie fortfahren, diese Seite zu verwenden, nehmen wir an, dass Sie damit einverstanden sind. Zur Datenschutzerklärung.
Die Wirkung von Lipocalinen auf humane dendritische Zellen
Details
Das rekombinante Katzenallergen rFel d 4 und das putative humane Homolog rFel d 4 like lipocalin werden in vitro auf ihre Wirkung auf humane dendritische Zellen verglichen, welche zu den potentesten Antigen-präsentierenden Zellen des Immunsystems gehören. Dabei wird die Antigenaufnahme, Reifungsinduktion und Produktion von TH1/TH2-bestimmenden Zytokinen im Rahmen der Immunantwort mit verschiedenen Methoden (Immunfluoreszenz, FACS, ELISA) untersucht. In der vorliegenden Arbeit wird gezeigt, dass die beiden homologen Lipocaline rFel d 4 und rFel d 4 like lipocalin unterschiedliche Effekte auf humane DZ haben: Obwohl sich die beiden Lipocaline stark ähnlich sind, induziert das Katzenallergen eine für allergische Reaktionen typische TH2-Immunantwort, während das nicht-allergene Homolog eine TH1-Antwort auslöst.
Autorentext
Fabian S. Gamper, geboren am 27.01.1989 in Innsbruck (A), besuchte das wissenschaftliche Realgymnasium J.Ph. Fallmerayer in Brixen, Südtirol, und studierte Mikrobiologie an der Leopold Franzens Universität in Innsbruck. Dieses Manuskript ist im Rahmen der wissenschaftlichen Mitarbeit im MB-Labor an der Universitätsklinik Innsbruck entstanden.
Weitere Informationen
- Allgemeine Informationen
- GTIN 09783639842845
- Sprache Deutsch
- Größe H220mm x B150mm x T6mm
- Jahr 2015
- EAN 9783639842845
- Format Kartonierter Einband
- ISBN 978-3-639-84284-5
- Veröffentlichung 22.04.2015
- Titel Die Wirkung von Lipocalinen auf humane dendritische Zellen
- Autor Fabian Sebastian Gamper
- Untertitel Katzenallergen Fel d 4 und Fel d 4 like lipocalin
- Gewicht 161g
- Herausgeber AV Akademikerverlag
- Anzahl Seiten 96
- Genre Nichtklinische Fächer